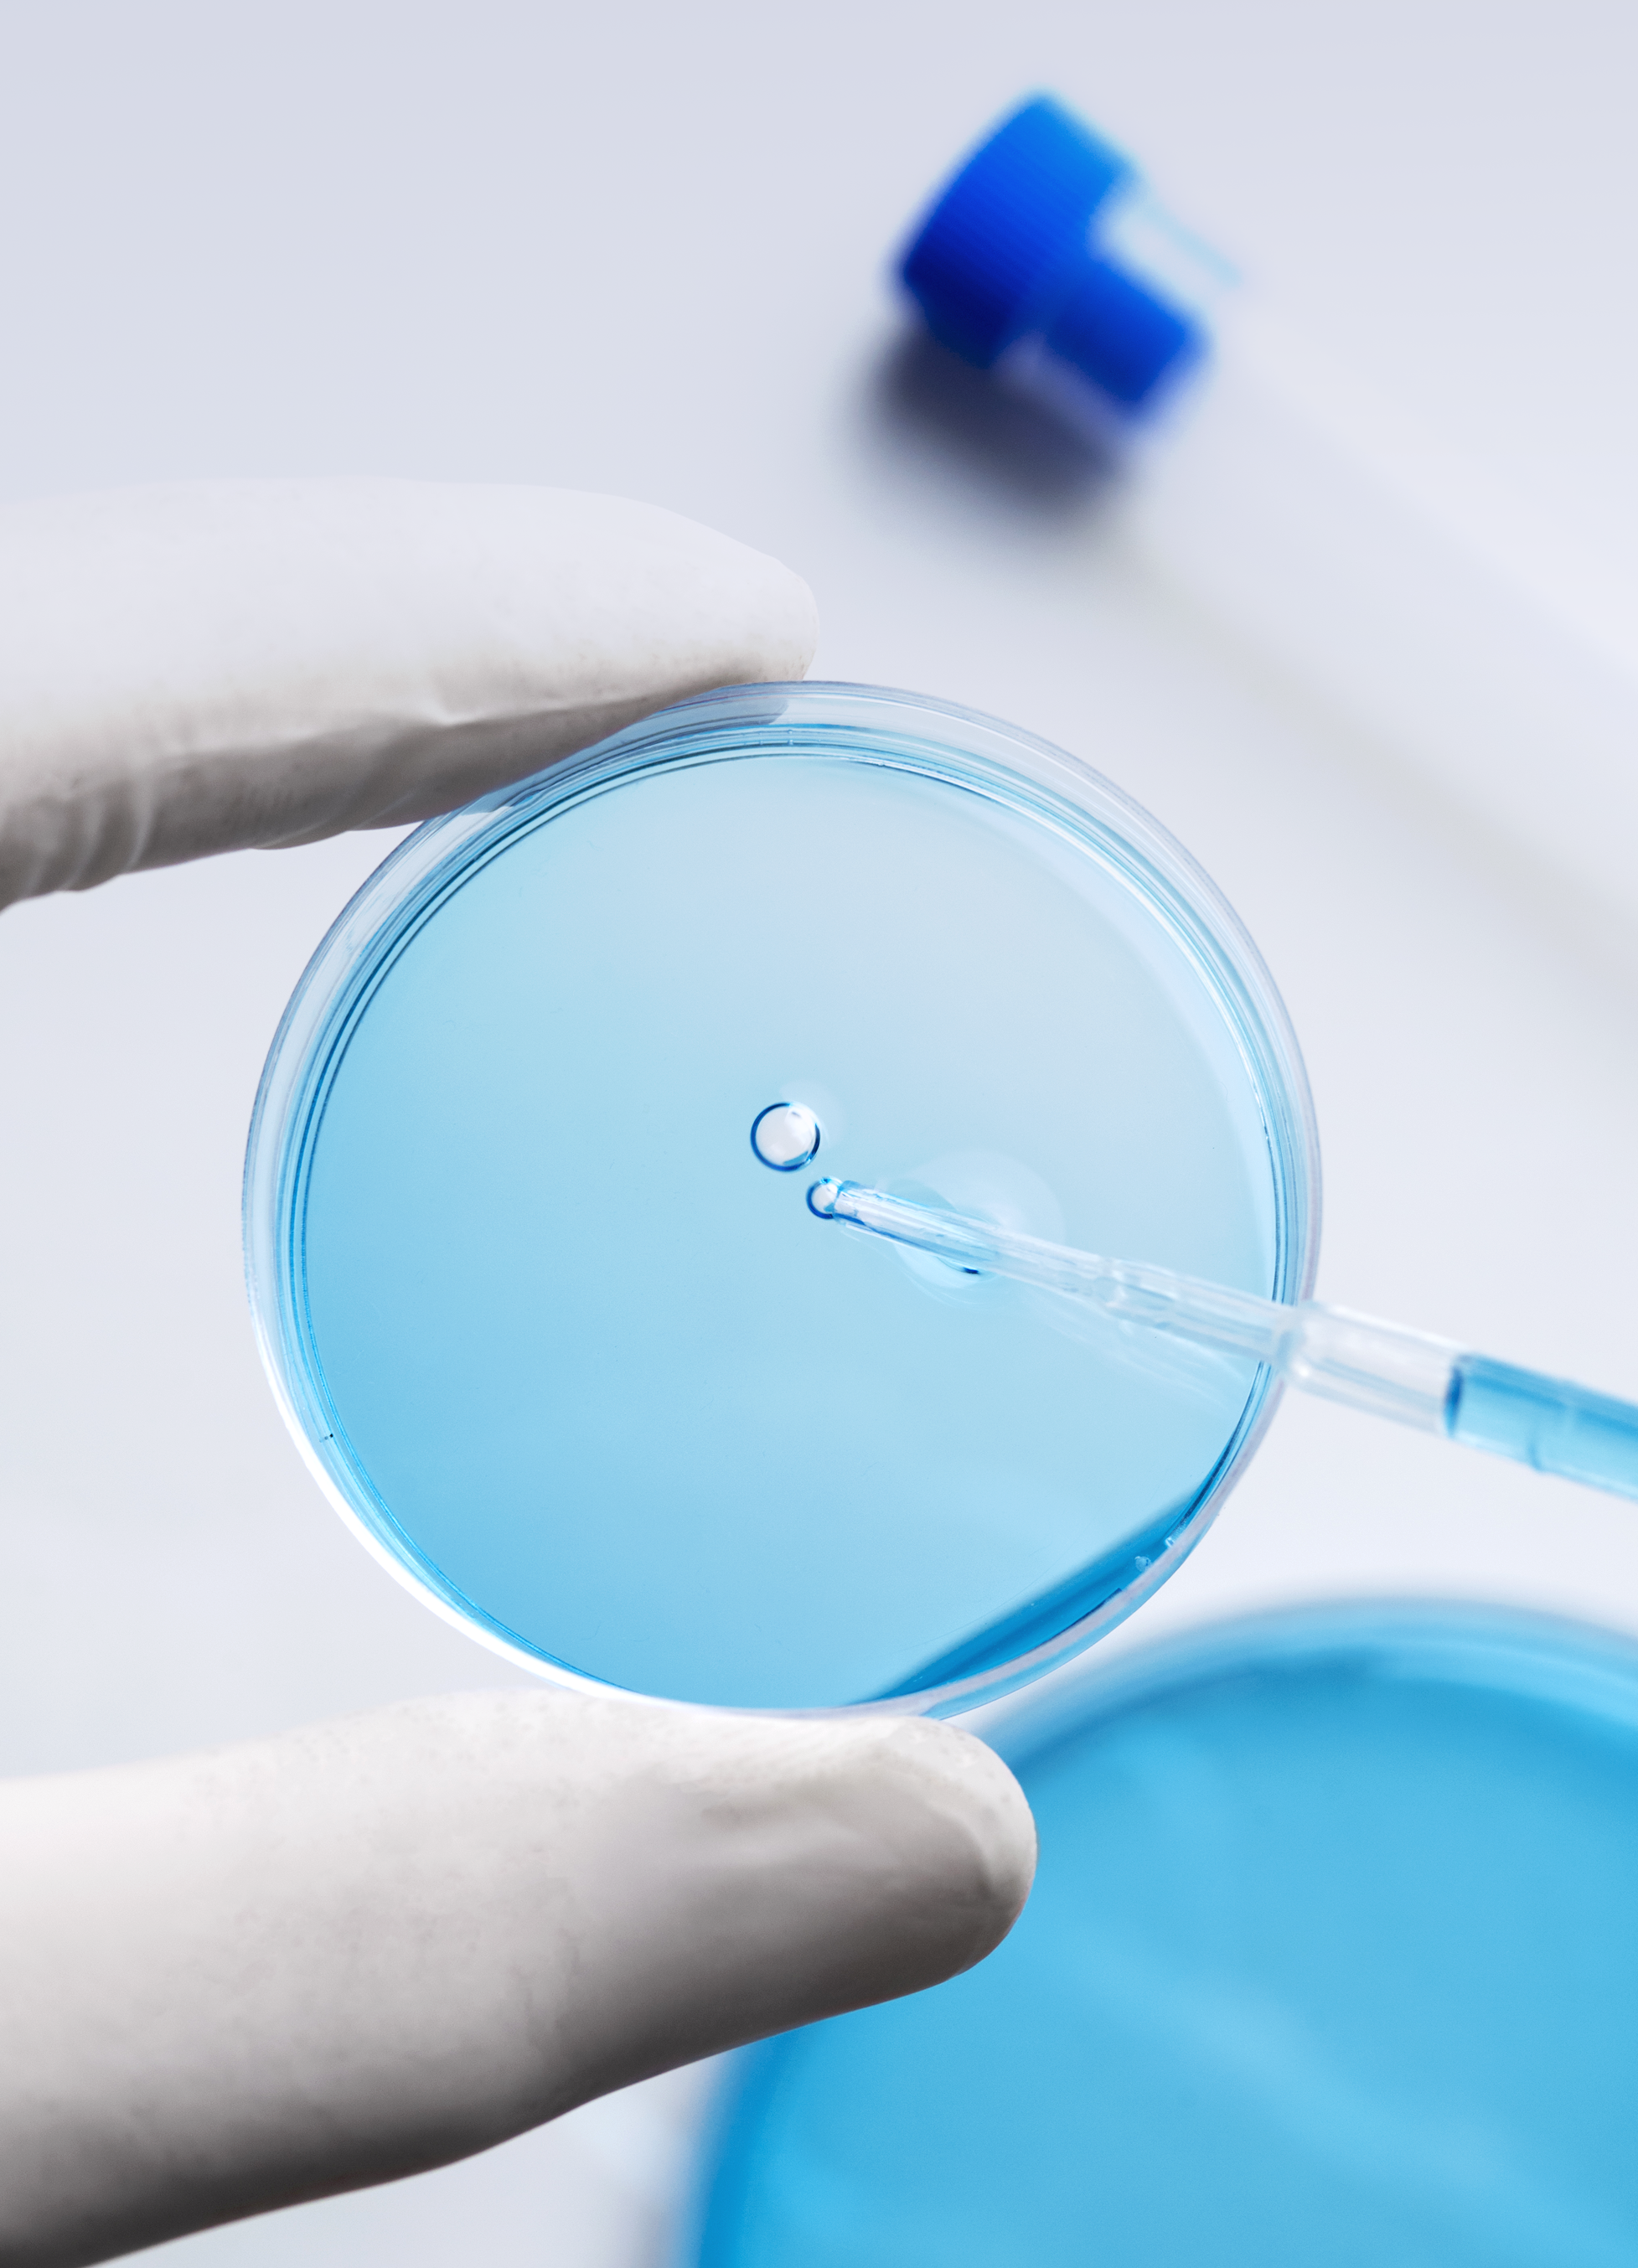

Research Peptides 
Free Ebook
Why This Guide Is Essential:
- Comprehensive research synthesis from peer-reviewed studies in peptide science
- In-depth analysis of key peptides including BPC-157, TB-500, and growth hormone secretagogues
- Strategic peptide combinations for optimized research outcomes
Peptides are short chains of amino acids that act as biological signaling molecules, orchestrating countless processes in the human body. From muscle growth and tissue repair to immune function and cognitive enhancement, these remarkable compounds are at the forefront of scientific research. Download it now to take a deeper dive into the science!
Unlocking The Body's Ultimate Potential
The Definitive Guide to Understanding Peptide Research.
Please provide a valid email address to receive the download link.